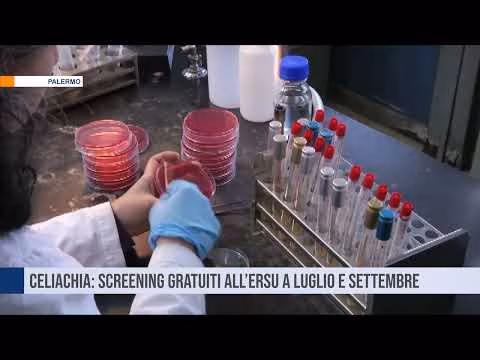
Celiachia: screening gratuiti all’Ersu di Palermo a luglio e settembre

Celiachia: screening gratuiti all’Ersu di Palermo a luglio e settembre
https://www.youtube.com/watch?v=w4v2xs5ySeM
A Palermo, screening gratuiti sulla celiachia nella residenza universitaria Ersu nei mesi di luglio e settembre TELE ONE canale 16 in tutta la Sicilia, in diretta streaming su www.teleone.it, https://www.facebook.com/teleone.it e sull'App teleOne. All rights reserved – Questo video è protetto da copyright ed è espressamente vietato ogni utilizzo, riproduzione od uso, parziale o totale 

